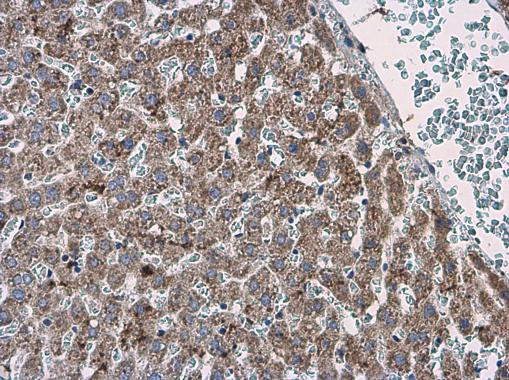
ABAT Antibody in Immunohistochemistry (Paraffin) (IHC (P))

Search
Invitrogen
ABAT Polyclonal Antibody
{{$productOrderCtrl.translations['antibody.pdp.commerceCard.promotion.promotions']}}
{{$productOrderCtrl.translations['antibody.pdp.commerceCard.promotion.viewpromo']}}
{{$productOrderCtrl.translations['antibody.pdp.commerceCard.promotion.promocode']}}: {{promo.promoCode}} {{promo.promoTitle}} {{promo.promoDescription}}. {{$productOrderCtrl.translations['antibody.pdp.commerceCard.promotion.learnmore']}}
图: 1 / 2
ABAT Antibody (PA5-78666) in IHC (P)


产品信息
PA5-78666
种属反应
宿主/亚型
分类
类型
抗原
偶联物
形式
浓度
规格
纯化类型
保存液
内含物
保存条件
运输条件
RRID
产品详细信息
Positive Control: mouse brain, rat brain
Predicted reactivity: Mouse (100%), Rat (100%).
Store product as a concentrated solution. Centrifuge briefly prior to opening the vial.
靶标信息
Accessory subunit of the mitochondrial membrane respiratory chain NADH dehydrogenase (Complex I), that is believed not to be involved in catalysis. Complex I functions in the transfer of electrons from NADH to the respiratory chain. The immediate electron acceptor for the enzyme is believed to be ubiquinone.
仅用于科研。不用于诊断过程。未经明确授权不得转售。
篇参考文献 (0)
生物信息学
蛋白别名: (S)-3-amino-2-methylpropionate transaminase; 4-aminobutyrate aminotransferase, mitochondrial; 4-aminobutyrate transaminase; beta-AlaAT I; beta-alanine oxoglutarate aminotransferase; FLJ17813; FLJ30272; GABA aminotransferase; GABA AT; GABA T; GABA transaminase; GABA transferase; GABA-AT; GABA-T; Gamma-amino-N-butyrate transaminase; hCG1984265; L AIBAT; L-AIBAT
基因别名: 9630038C02Rik; Abat; AI255750; beta-AlaAT; ENSMUSG00000051226; Gabaat; Gabat; Gm9851; I54; Laibat; X61497
UniProt ID: (Rat) P50554, (Mouse) P61922
Entrez Gene ID: (Rat) 81632, (Mouse) 268860